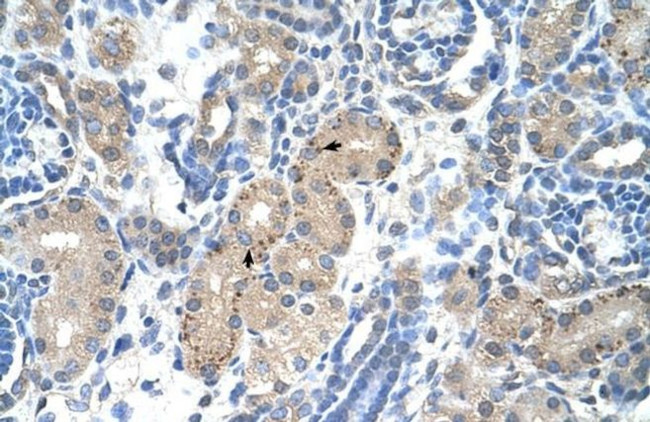
FOXR2 Antibody in Immunohistochemistry (IHC)

Search
Invitrogen
FOXR2 Polyclonal Antibody
{{$productOrderCtrl.translations['antibody.pdp.commerceCard.promotion.promotions']}}
{{$productOrderCtrl.translations['antibody.pdp.commerceCard.promotion.viewpromo']}}
{{$productOrderCtrl.translations['antibody.pdp.commerceCard.promotion.promocode']}}: {{promo.promoCode}} {{promo.promoTitle}} {{promo.promoDescription}}. {{$productOrderCtrl.translations['antibody.pdp.commerceCard.promotion.learnmore']}}


Please note: We are reviewing Western blot images included in the antibody testing data in our catalog, including those provided by third parties. Unless expressly labeled or annotated as “raw-unedited”, Western blot images included in the antibody testing data in our catalog may have been edited, optimized or otherwise adjusted for presentation.
产品信息
PA5-42252
种属反应
宿主/亚型
分类
类型
抗原
偶联物
形式
浓度
规格
纯化类型
保存液
内含物
保存条件
运输条件
RRID
产品详细信息
Peptide sequence: VDPNILCPLG SQEAPKPSGK EDLTNISPFP QPPQKDEGSN CSEDKVVESL
Sequence homology: Human: 100%
靶标信息
Forkhead-box (FOX) transcription factors are implicated in carcinogenesis through gene amplification, retroviral integration, or chromosomal translocation. Human FOXN6 mRNA was expressed in breast cancer cell line and primary breast cancer.
仅用于科研。不用于诊断过程。未经明确授权不得转售。